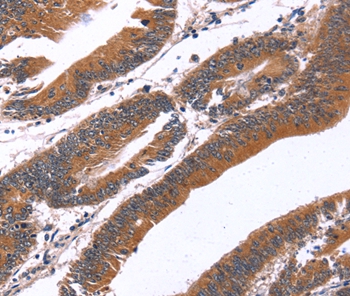

GREB1 Antibody (N-Terminus)
LS-C187137
ApplicationsWestern Blot
Product group Antibodies
TargetGREB1
Overview
- SupplierLifeSpan BioSciences
- Product NameGREB1 Antibody (N-Terminus)
- Delivery Days Customer14
- ApplicationsWestern Blot
- Applications SupplierWB
- CertificationResearch Use Only
- ClonalityPolyclonal
- Concentration0.5 mg/ml
- ConjugateUnconjugated
- Estimated Purity...
- Gene ID9687
- Target nameGREB1
- Target descriptiongrowth regulating estrogen receptor binding 1
- Target synonymsgene regulated by estrogen in breast cancer; gene regulated in breast cancer 1 protein; growth regulation by estrogen in breast cancer 1; protein GREB1
- HostRabbit
- Storage Instruction-20°C,2°C to 8°C
- UNSPSC12352203